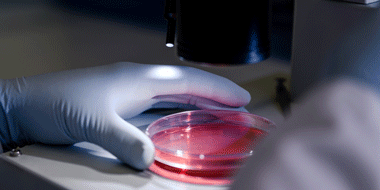

Vision Private Equity
Our single vintage, institutional-style strategy, constructed from rigorously assessed, high-conviction opportunities across primary, secondary and co-investments.
What’s new
Who we are
The Vision Programme
Vision, our flagship annual private equity programme, harnesses the potential of a single vintage, institutional-style portfolio constructed from rigorously assessed, high-conviction opportunities across primary, secondary and co-investments.
What sets us apart

|
Stringent selection A rigorous high conviction approach to strategy, manager selection and portfolio construction filters best in class opportunities Institutional access Vision invests alongside HSBC itself, benefitting from the bank’s vast scale and network to access opportunities beyond the reach of many Proven expertise HSBC Asset Management’s deep expertise supports sound investment decisions, with a track record that speaks for itself |
|
“Our strong market network and the scale of our platform equips us with the ability to source and originate high-quality primary, secondary, and co-investment deal flow to provide a range of compelling investment opportunities for our clients globally.”
|
|
What we do
A glimpse into the investments from previous vintages
Leadership team

William Benjamin Head of Alternative Solutions |

James Wilkinson Head of Private Equity Fund Investments |

Kutty Dutta Head of Secondaries |

Patrick Sixsmith Head of Co-investments |
Contact us
Key Risks
Further information on the potential risks can be found in the Prospectus or Offering Memorandum.
Risk Considerations. There is no assurance that a portfoliowill achieve its investment objective or will work under all market conditions. The value of investments may go down as well as up and you may not get back the amount originally invested. Portfolios may be subject to certain additional risks, which should be considered carefully along with their investment objectives and fees.
- Illiquidity: An investment in the Fund is a long term illiquid investment. By their nature, the Fund’s investments will not generally be exchange traded. These investments will be illiquid.
- Long term horizon: Investors should expect to be locked-in for the full term of the investment.
- Economic conditions: The economic cycle and prevailing interest rates will impact the attractiveness of the underlying investments. Economic activity and sentiment also impacts the performance of underlying companies and will have a direct bearing on the ability of companies to keep up with interest and principal repayments.
- Loans to private companies: The Fund will invest in loans to medium sized privately owned companies. There are specific risks associated with lending to such companies, including that they may have limited financial resources, access to capital and higher funding costs. They may also be more vulnerable to market, key-man and other risks and their accounts are not typically published.
- Valuation: These investments may have no or a limited liquid market, and other investments including those in respect of loans and securities of private companies, may be based on estimates which cannot be marked to market until sale. The valuation of the underlying investments is therefore inherently opaque.
- Fund Risk: Investments into this Fund may, among other risks, be negatively affected by adverse regulatory developments or reform, credit risk and counterparty risk. The credit market bears idiosyncratic risks such as borrower fraud, borrower bankruptcy, prepayment risk, security enforceability risk, subordination risk and lender liability risk.
- Investor’s Capital At Risk: Investors may lose the entirety of invested capital.